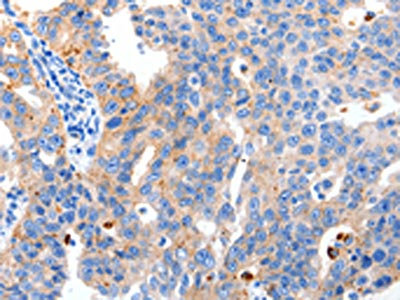

MAPK10 Antibody
-
中文名稱:MAPK10兔多克隆抗體
-
貨號:CSB-PA950615
-
規(guī)格:¥1100
-
圖片:
-
The image on the left is immunohistochemistry of paraffin-embedded Human breast cancer tissue using CSB-PA950615(MAPK10 Antibody) at dilution 1/10, on the right is treated with synthetic peptide. (Original magnification: ×200)
-
Gel: 10%SDS-PAGE, Lysate: 40 μg, Lane: 293T cells, Primary antibody: CSB-PA950615(MAPK10 Antibody) at dilution 1/200, Secondary antibody: Goat anti rabbit IgG at 1/8000 dilution, Exposure time: 20 minutes
-
-
其他:
產(chǎn)品詳情
-
Uniprot No.:
-
基因名:
-
別名:c Jun kinase 3 antibody; c-Jun N-terminal kinase 3 antibody; cJun N terminal kinase 3 antibody; FLJ12099 antibody; FLJ33785 antibody; JNK3 alpha protein kinase antibody; JNK3 antibody; JNK3A antibody; MAP kinase 10 antibody; MAP kinase antibody; MAP kinase p49 3F12 antibody; MAPK 10 antibody; Mapk10 antibody; MGC50974 antibody; mitogen activated protein kinase 10 antibody; Mitogen-activated protein kinase 10 antibody; MK10_HUMAN antibody; p493F12 antibody; p54bSAPK antibody; PRKM10 antibody; protein kinase mitogen activated 10 antibody; SAPK1b antibody; Stress activated protein kinase 1b antibody; stress activated protein kinase beta antibody; Stress activated protein kinase JNK3 antibody; Stress-activated protein kinase JNK3 antibody
-
宿主:Rabbit
-
反應(yīng)種屬:Human,Mouse,Rat
-
免疫原:Synthetic peptide of Human MAPK10
-
免疫原種屬:Homo sapiens (Human)
-
標(biāo)記方式:Non-conjugated
-
抗體亞型:IgG
-
純化方式:Antigen affinity purification
-
濃度:It differs from different batches. Please contact us to confirm it.
-
保存緩沖液:-20°C, pH7.4 PBS, 0.05% NaN3, 40% Glycerol
-
產(chǎn)品提供形式:Liquid
-
應(yīng)用范圍:ELISA,WB,IHC
-
推薦稀釋比:
Application Recommended Dilution ELISA 1:1000-1:5000 WB 1:500-1:2000 IHC 1:5-1:20 -
Protocols:
-
儲存條件:Upon receipt, store at -20°C or -80°C. Avoid repeated freeze.
-
貨期:Basically, we can dispatch the products out in 1-3 working days after receiving your orders. Delivery time maybe differs from different purchasing way or location, please kindly consult your local distributors for specific delivery time.
-
用途:For Research Use Only. Not for use in diagnostic or therapeutic procedures.
相關(guān)產(chǎn)品
靶點(diǎn)詳情
-
功能:Serine/threonine-protein kinase involved in various processes such as neuronal proliferation, differentiation, migration and programmed cell death. Extracellular stimuli such as proinflammatory cytokines or physical stress stimulate the stress-activated protein kinase/c-Jun N-terminal kinase (SAP/JNK) signaling pathway. In this cascade, two dual specificity kinases MAP2K4/MKK4 and MAP2K7/MKK7 phosphorylate and activate MAPK10/JNK3. In turn, MAPK10/JNK3 phosphorylates a number of transcription factors, primarily components of AP-1 such as JUN and ATF2 and thus regulates AP-1 transcriptional activity. Plays regulatory roles in the signaling pathways during neuronal apoptosis. Phosphorylates the neuronal microtubule regulator STMN2. Acts in the regulation of the amyloid-beta precursor protein/APP signaling during neuronal differentiation by phosphorylating APP. Participates also in neurite growth in spiral ganglion neurons. Phosphorylates the CLOCK-ARNTL/BMAL1 heterodimer and plays a role in the photic regulation of the circadian clock. Phosphorylates JUND and this phosphorylation is inhibited in the presence of MEN1.
-
基因功能參考文獻(xiàn):
- Mapk10 expression was regulated by miR27a-3p in nasopharyngeal carcinoma.Mapk10 gene was down-regulated in the nasopharyngeal carcinoma cells. PMID: 28393229
- Peptide mini-scaffold facilitates JNK3 activation in cells. PMID: 26868142
- Study found that JNK3 levels are increased in brain tissue and CSF from patients with Alzheimer disease and CSF levels could reflect the rate of cognitive decline PMID: 25455349
- Data indicate that tetra-substituted pyridinylimidazoles were designed as dual inhibitors of c-Jun N-terminal kinase (JNK) 3 and p38alpha mitogen-activated protein (MAP) kinase, and both kinases may be involved in the progression of Huntington's disease. PMID: 25475894
- JNK3 is required for the antiapoptotic effects of exendin 4 PMID: 25025079
- analysis of the unique mechanisms by which JNK1beta1 is regulated PMID: 25178256
- Mitogen-activated protein kinase 10 JNK3 alpha (JNK3apha2)binds to both domains of arrestin-3. PMID: 24412749
- miR-29b mRNA, MAPK10 protein expression, and ATG9A protein expression are closely related to chemosensitivity of ovarian carcinoma. PMID: 24767251
- Subtle structural mechanisms for allosteric signaling between the peptide-binding site and activation loop of human JNK3. PMID: 23142346
- reduced JNK3 activity has potentially deleterious effects on neuronal function via altered regulation of a set of post-synaptic proteins. PMID: 23329067
- Silent scaffolds: inhibition OF c-Jun N-terminal kinase 3 activity in cell by dominant-negative arrestin-3 mutant. PMID: 22523077
- [review] This review focuses on delineating the role of scaffold proteins, especially that of JNK3 as a target, on the regulation of JNK signaling in neurons. PMID: 21321401
- Arrestin-3 acts as a "true" scaffold, facilitating JNK3alpha2 phosphorylation by bringing it and MAP kinase kinase (MKK)4 together. PMID: 22047447
- The results suggest the possible involvement of CaMKII and JNK3 in soman-induced long-term neurotoxicity. PMID: 21041242
- results suggest that MAPK10 may have a proapoptotic function and could function as a tumor-suppressor gene in chromophobe renal cell carcinoma PMID: 21166945
- Shares a promoter region with the tightly linked gene encoding Fas-associated phosphatase-1. PMID: 12436199
- interaction of free arrestins with JNK3 and Mdm2 and their ability to regulate subcellular localization of these proteins may play an important role in the survival of photoreceptors and other neurons PMID: 16737965
- Arrestin in all conformations binds JNK3 comparably, whereas Mdm2 preferentially binds cone arrestin 'frozen' in the basal state. PMID: 17680991
- JNK3 recruits MKK4 to the beta-arrestin-2 scaffold complex by binding to the MAPK docking domain (D-domain) located within the N terminus of MKK4. PMID: 18408005
顯示更多
收起更多
-
相關(guān)疾病:A chromosomal aberration involving MAPK10 has been found in a single patient with pharmacoresistant epileptic encephalopathy. Translocation t(Y;4)(q11.2;q21) which causes MAPK10 truncation.
-
亞細(xì)胞定位:Cytoplasm. Membrane; Lipid-anchor. Nucleus. Mitochondrion.
-
蛋白家族:Protein kinase superfamily, CMGC Ser/Thr protein kinase family, MAP kinase subfamily
-
組織特異性:Specific to a subset of neurons in the nervous system. Present in the hippocampus and areas, cerebellum, striatum, brain stem, and weakly in the spinal cord. Very weak expression in testis and kidney.
-
數(shù)據(jù)庫鏈接:
Most popular with customers
-
-
YWHAB Recombinant Monoclonal Antibody
Applications: ELISA, WB, IHC, IF, FC
Species Reactivity: Human, Mouse, Rat
-
Phospho-YAP1 (S127) Recombinant Monoclonal Antibody
Applications: ELISA, WB, IHC
Species Reactivity: Human
-
-
-
-
-